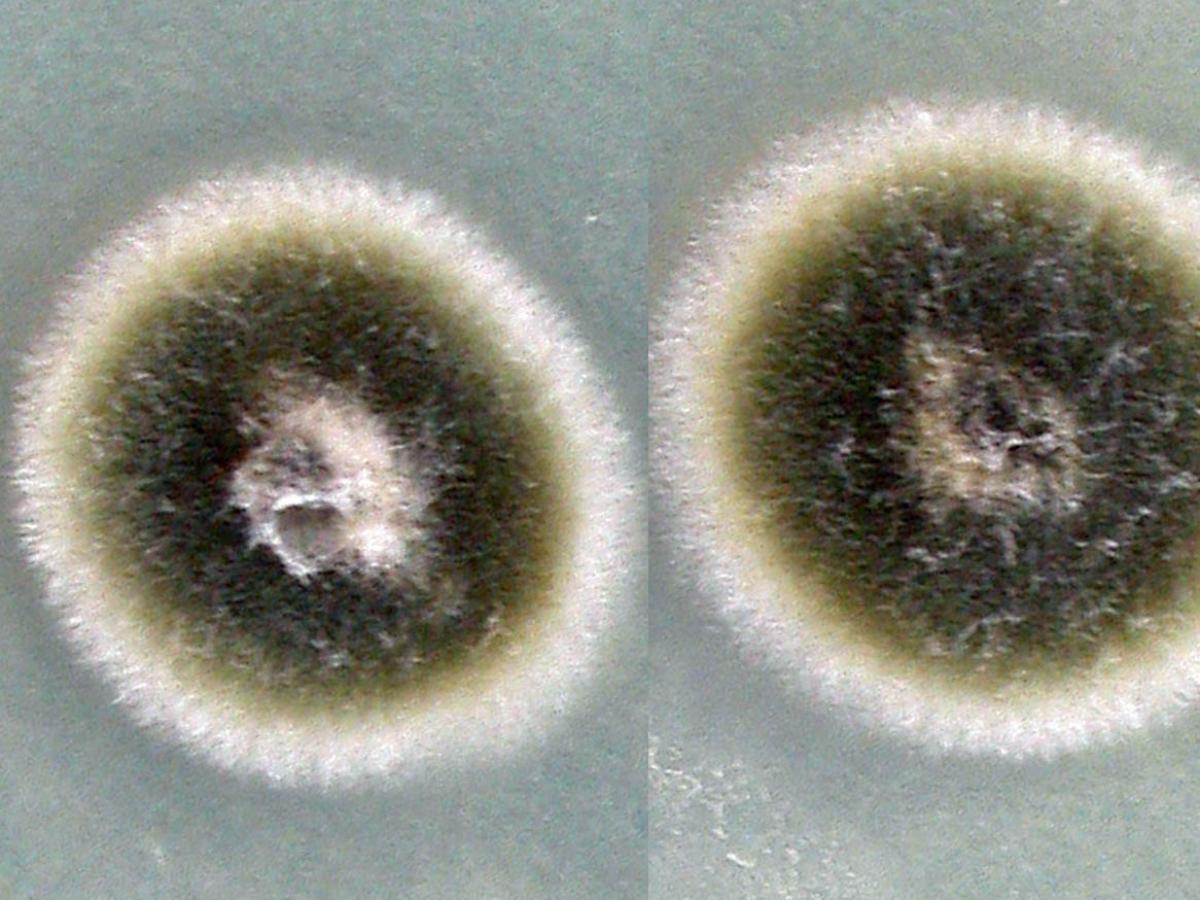
Culture

Status message
Correct! Excellent, you have really done well. Please find additional information below.
Unknown 39 = Alternaria alternata
Clinical presentation: Subcutaneous phaeohyphomycosis following a non-penetrating injury.

Culture: Colonies are fast growing, black to olivaceous-black or greyish, and are suede-like to floccose.
Microscopy: Microscopically, branched acropetal chains (blastocatenate) of multicelled conidia (dictyoconidia) are produced sympodially from simple, sometimes branched, short or elongate conidiophores. Conidia are obclavate, obpyriform, sometimes ovoid or ellipsoidal, often with a short conical or cylindrical beak, pale brown, smooth-walled or verrucose. Temperature: optimum 25-28C; maximum 31-32C. RG-1 organism.

Comment: Alternaria is a ubiquitous genus containing common saprophytes in soil and air, and plant pathogens. Although usually seen as saprophytic contaminants, Alternaria species in particular A. alternata and A. infectoria are recognised causative agents of subcutaneous phaeohyphomycosis and mycotic keratitis. They are a rare cause of onychomycosis, usually following trauma to the nail.
About Alternaria Back to virtual assessment